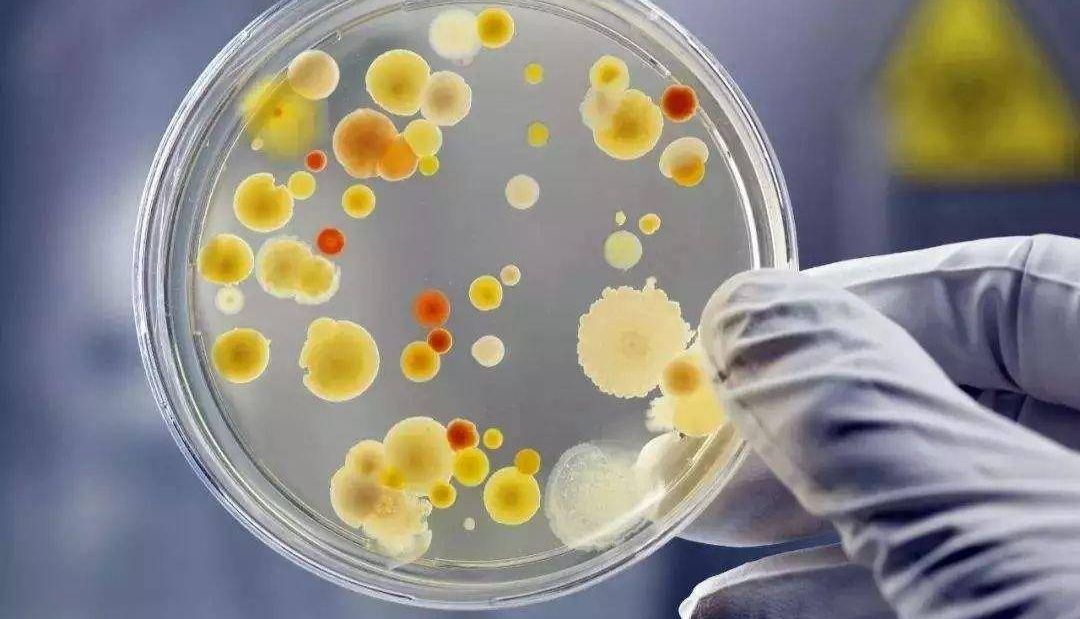
菌落总数平板计数原则与计数准确性的关键

上海远慕生物科技有限公司品牌商
14 年
手机商铺
商家活跃:
产品热度:
- NaN
- 0
- 0
- 2
- 2
全部产品
- 查看全部分类
- 标准品/对照品
- 进口标准品
- 进口标准品 标准物质
- 化学试剂
- 生化试剂A
- 生化试剂B
- 生化试剂C
- 抗体
- 抗体系列
- 培养基系列
- 血清
- PCR检测试剂盒
- 检测试剂盒
- ELISA试剂盒
- 人ELISA试剂盒说明书
- 大鼠ELISA试剂盒说明书
- 小鼠ELISA试剂盒说明书
- 兔ELISA试剂盒说明书
- 其他ELISA试剂盒说明书
- 猪ELISA试剂盒说明书
- ELISA试剂盒价格
- 免费代测ELISA试剂盒
- 特价促销-试剂盒
- 特价促销-标准品
- 特价促销-生化试剂
- 染色液
- 染色液缓冲液
- 免疫组化及相关实验试剂
- 金标试剂盒
- Omega 最新试剂盒系列
- 实验室常用耗材
- 分离材料及耗材类
- 水质检测系列
- 季铵盐阳离子试剂
- 电泳类
- 2015新品推荐
- Roche
- Epicentre
- 溶液
- Lucigen
- Immunoreagents
- Advanced Biomatrix
- Phytotech
- Cell Biolabs
- Agrisera
- R&D Systems
- 质粒载体
品牌商
上海远慕生物科技有限公司
入驻年限:14 年
- 联系人:
王宇豪
- 所在地区:
上海 嘉定区
- 业务范围:
试剂、抗体、细胞库 / 细胞培养、ELISA 试剂盒、技术服务、耗材、书籍 / 软件、论文服务、原辅料包材、医疗器械、体外诊断
- 经营模式:
经销商 代理商 科研机构